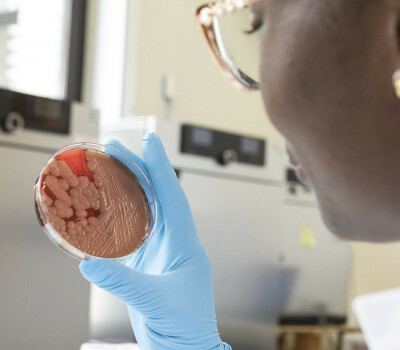

Simplified Blood Culture System (SIMBLE)

Summary
The SIMBLE project is designed to evaluate Bactinsight, our recently developed simplified blood culture system, which consists of two modules:
A portable measurement device (turbidity metre) which detects bacterial growth in blood culture bottles, based on the turbidity of the culture medium
Blood culture bottles with optimised formulation
An additional module on the Bactinsight system contains a lens-free microscope, which simplifies and expedites the identification of the causative organisms. Bactinsight will be evaluated across two field sites in Western Africa by comparing it to the reference systems already in use. In addition, we will evaluate the usability, acceptability, adoptability and performance of the system.
The Bactinsight blood culture bottles will be produced on-site in Benin, in a production container production facility that will be installed on the Cotonou campus at the start of the project. With this production facility, we want to enforce local production not only during the SIMBLE study, but also after.
The SIMBLE project ended on 30 September 2025.
Project
Clinical diagnostic trial in Western Africa of a simplified blood culture system to improve healthcare in low-resource settings
Period
July 2021 – September 2025
Contact
Liselotte Hardy
Coordinating investigator
✉ lhardy@itg.be

Consortium partners
Liselotte Hardy – Institute of Tropical Medicine (ITM), Belgium
Roel Baets – Ghent University (UGent), Belgium
Olivier Vandenberg – Université Libre de Bruxelles (ULB), Belgium
Pierre Marcoux – Commissariat à l'Energie Atomique et aux Energies Alternatives (CEA), France
Marti Asensio – Reactivos Para Diagnóstico (RPD), Spain
Dissou Affolabi – Centre National Hospitalier Universitaire de Pneumo-Phtisiologie (CNHU-PPC), Benin
Adama Zida – Centre Hospitalier Universitaire Yalgado Ouédraogo (CHUYO), Burkina Faso

Publication alert!
We are proud to share our latest publication in Scientific Reports. In this study, we evaluated the performance of BactInsight, a simplified and affordable blood culture system designed for resource-limited settings, using a simulated test design under reference laboratory conditions. Our findings demonstrate that this low-cost system can achieve performance comparable to automated platforms while remaining robust and practical for challenging environments, but also highlight some points for improvement.
Access to reliable blood culture diagnostics remains a major gap in many regions, directly affecting sepsis management and antimicrobial stewardship. Expanding access to quality microbiology diagnostics is essential for improving patient outcomes globally. This work represents a step towards that goal.
https://doi.org/10.1038/s41598-026-36676-y
View publications
2026
Barbé B, Cornelis J, Ghomashi M, Corsmit E, Genbrugge E, Marchesin E, Li Y, Baets R, Jacobs J, Hardy H. Performance evaluation of the BactInsight simplified blood culture system developed for resource-limited settings using a simulated test design. Sci Rep. 2026 Jan 22;16(1):6004. https://doi.org/10.1038/s41598-026-36676-y
2024
Douarre C, David D, Fangazio M, Picard E, Hadji E, Vandenberg O, Barbé B, Hardy L, Marcoux P. Simple Imaging System for Label-Free Identification of Bacterial Pathogens in Resource-Limited Settings. Volume 2024, Article ID 6465280. https://doi.org/10.1155/2024/6465280
2023
Massou F, Gouton A O, Palomo B, Senou J-C, Porta A, Barbé B, Affolabi D, Hardy L. Laboratory-on-a-ship: a microbiology culture media production facility in a sea container for local production in low-resource settings. Lancet Microbe March 9, 2023. https://doi.org/10.1016/S2666-5247(23)00070-8
2022
Barbé B, Corsmit E, Jans J, Kaur K, Baets R, Jacobs J, Hardy L. Pilot Testing of the “Turbidimeter”, a Simple, Universal Reader Intended to Complement and Enhance Bacterial Growth Detection in Manual Blood Culture Systems in Low-Resource Settings. Diagnostics. 2022; 12(3):615. https://doi.org/10.3390/diagnostics12030615
Ombelet S, Natale A, Ronat JB, Kesteman T, Vandenberg O, Jacobs J, Hardy L. Biphasic versus monophasic manual blood culture bottles for low-resource settings: an in-vitro study. Lancet Microbe. 2022 Feb;3(2):e124-e132. doi: 10.1016/S2666-5247(21)00241-X
Ombelet S, Kpossou G, Kotchare C, Agbobli E, Sogbo F, Massou F, Lagrou K, Barbé B, Affolabi D, Jacobs J. Blood culture surveillance in a secondary care hospital in Benin: epidemiology of bloodstream infection pathogens and antimicrobial resistance. BMC Infect Dis. 2022 Feb 3;22(1):119. doi: 10.1186/s12879-022-07077-z.
Ombelet S, Natale A, Ronat JB, Vandenberg O, Jacobs J, Hardy L. Considerations in evaluating equipment-free blood culture bottles: A short protocol for use in low-resource settings. PLoS One. 2022 Apr 25;17(4):e0267491. doi: 10.1371/journal.pone.0267491. eCollection 2022.
2021
Orekan J, Barbé B, Oeng S, Ronat JB, Letchford J, Jacobs J, Affolabi D, Hardy L. Culture media for clinical bacteriology in low- and middle-income countries: challenges, best practices for preparation and recommendations for improved access. Clin Microbiol Infect. 2021 May 18:S1198-743X(21)00239-1. doi: 10.1016/j.cmi.2021.05.016.
Pierre Marcoux (CEA-LETI) and Liselotte Hardy (ITM) are co-editors of a special issue for the journal “Frontiers in Cellular and Infection Microbiology” dedicated to “Phenotypic identification of micro-organisms through label-free optic methods”
Liselotte Hardy (ITM) is editor of a special issue for the journal “Diagnostics” that is fully dedicated to “Point-of-care Diagnostics for Low-Resource Settings”
View oral / poster presentations
2026
At the European Congress of Clinical Microbiology and Infectious Diseases (ESCMID Global), 17-21 April 2026 (Munich):
Barbé B, Massou F, Beloum A, Kpossou G, Cornelis J, Genbrugge E, Zida A, Affolabi D, Hardy L. Field evaluation of a simplified blood culture system (BactInsight) developed for resource-limited settings.
2025
At the ITM colloquium, 4-6 November 2025 (Antwerp):
Barbé B, Massou F, Palomo B, Marcoux P, Li Y, Zida A, Vandenberg O, Kpossou G, Nguyen TT, Affolabi D, Hardy L, on behalf of the SIMBLE consortium. Lessons learned from the SIMBLE trial evaluating a simplified blood culture system in Belgium, Benin and Burkina Faso.
Nguyen TT, Agbo I, Nignan B, Barbé B, Hardy L, Peeters Grietens K. Social factors influencing the use and acceptability of a new diagnostic tool for detecting bloodstream infections in resource-limited field settings: findings from Benin and Burkina Faso
Douarre C, David D, Fangazio M, Picard E, Hadji E, Vandenberg O, Affolabi D, Kpossou G, Zida A, Barbé B, Hardy L, Marcoux P. Simple imaging system for optical identification of pathogens in Resource-Limited Settings.
Cornelis J, Hardy L, Li Y. Design of a prototype universal blood culture automate for use in low resource settings.
At the 12th EDCTP forum, 15-20 June 2025 (Kigali):
Affolabi D. Laboratory-on-a-ship, an EDCTP2-financed pilot study on local production of culture media in Benin
2024
At the Knowledge for Growth, 16 May 2024 (Antwerp):
Cornelis J, Barbé B, Ghomashi M, Corsmit E, Genbrugge E, Marchesin F, Yanlu L, Baets R, Jacobs J, Hardy L. Development of a diagnostic prototype for detecting bloodstream infections: the BactInsight turbidimeter.
At the European Congress of Clinical Microbiology and Infectious Diseases (ESCMID Global), 27-30 April 2024 (Barcelona):
Barbé B, Cornelis J, Ghomashi M, Corsmit E, Genbrugge E, Marchesin F, Li Y, Baets R, Jacobs J, Hardy L. The BactInsight system: a simplified blood culture system developed for resource-limited settings, performs well compared to an automated reference system in a simulated test design
2023
At ASLM, 12-15 December 2023 (Cape Town):
Douarre C, David D, Picard E, Hadji E, Marcoux P. Diagnosis of bacterial bloodstream infections in low-resource settings: How can imaging and AI help? Invited lecture in the session “Transforming diagnostics: the role of AI, robotic technology and computer science"
At the Annual IEEE Photonics Benelux Symposium, 23-24 November 2023 (Ghent):
Cornelis J, Ghomashi M, Corsmit E, Marchesin F, Hardy L, Baets R, Li Y. Development of an optical/electronic system for rapid detection of bacterial infection.
At the EDCTP Forum, 8-10 November 2023 (Paris):
Douarre C, Fangazio M, David D, Picard E, Hadji E, Vandenberg O, Hardy L, Marcoux P. Simple imaging system for optical label-free identification of bacterial clinical isolates in Low-Resource Settings (LRS). BMJ Global Health 2023;8:A48.
Barbé B, Corsmit E, Ghomashi M, Marchesin F, Cornelis J, Kaur K, Baets R, Jacobs J, Hardy L. Access to diagnosis of bloodstream infections in low-resource settings: evaluation of the improved “Turbidimeter” prototype to detect bacterial growth in manual blood culture systems. BMJ Global Health 2023;8:A75-A76.
At the European Congress of Clinical Microbiology and Infectious Diseases (ECCMID), 15 to 18 April 2023 (Copenhagen):
Massou F, Gouton A O, Palomo B, Senou J-C, Porta A, Barbé B, Affolabi D, Hardy L. Improving local production of quality-assured culture media in resource limited settings: design, manufacturing, transport, and installation of a microbiology production facility in a transportable container at Cotonou, Benin
2021
At the European Congress of Clinical Microbiology and Infectious Diseases (ECCMID), 9 to 12 July 2021 (online):
Barbé B, Corsmit E, Jans J, Kaur K, Baets R, Jacobs J, Hardy L. Equipment-free detection of bacterial growth in blood cultures for low-resource settings: proof of concept of the Turbidimeter.
Schiavone P, Zamoun I, Soulan S, Maire A, Gougis M, Marcoux PR, González TY, Mugnier G, Picard E, Zelsmann M, Hadji E, Peyrade D. Artificial intelligence and large field, high resolution lensless imaging for nondestructive, label-free identification directly on agar.
Marcoux PR, Fourar M, Hamerlinck H, Naessens E, Ngolè F, Benahmed S, Bergmann E, Decq D, Mermet X, Belafdil C, Gal O, Grohs P, Verhasselt B, Roch M, Schultz E. Nondestructive optical identification of pathogens on agar through laser backscattering.
Funding
Research themes

Antimicrobial Resistance
Read moreShare project on